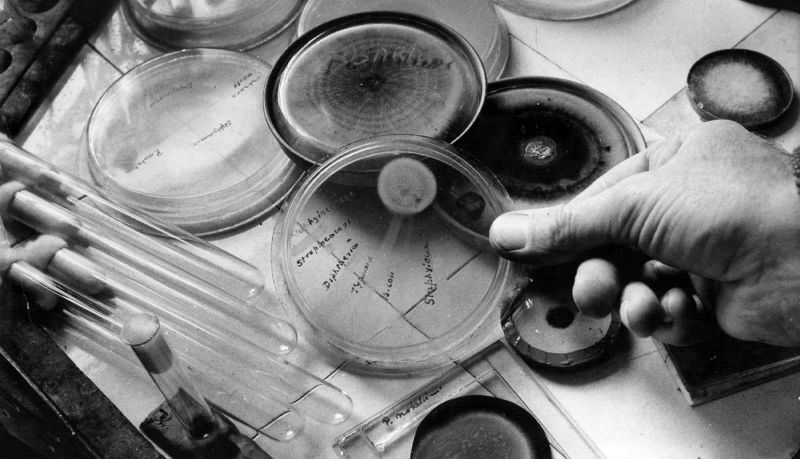
Случайные научные открытия

Случайные научные открытия
В 1928 году английский ученый-бактериолог Александр Флеминг провел обычный опыт исследования защиты организма человека от инфекционных заболеваний. В результате совершенно случайно он выяснил, что обычная плесень синтезирует вещество, уничтожающее возбудители инфекции, и обнаружил молекулу, которую назвал пенициллином.
А 13 сентября 1929 года на заседании Медицинского исследовательского клуба при Лондонском университете Флеминг представил свое открытие.
Далеко не все научные открытия были сделаны после длительных экспериментов и изнурительных размышлений. Иной раз исследователи приходили к совершенно неожиданным результатам, сильно отличающимся от ожидаемых. И итог оказывался куда интереснее: так, в поисках философского камня в 1669 году открыл белый фосфор гамбургский алхимик Хенниг Бранд. «Случай, бог-изобретатель», как назвал его Александр Пушкин, помогал и другим исследователям. Мы собрали десять таких удивительных примеров.

1. Микроволновая печь
Инженер из Raytheon Corporation Перси Спенсер в 1945 году работал над проектом, связанным с созданием радаров. Во время тестирования магнетрона ученый заметил, что шоколадка в его кармане растаяла. Так Перси Спенсер понял, что микроволновое излучение может нагревать продукты. В том же году компания Raytheon Corporation запатентовала микроволновую печь.

2. Рентгеновские лучи
Из любопытства поместив руку перед электронно-лучевой трубкой, в 1895 году Вильгельм Рентген и увидел ее изображение на фотопластинке, позволяющее рассмотреть чуть ли не каждую кость. Так Вильгельм Рентген открыл одноименный метод.

3. Заменитель сахара
Вообще-то Константин Фальберг изучал каменноугольные смолы. Как-то раз (мама, видимо, не научила его мыть руки перед едой) он заметил, что булочка почему-то кажется ему очень сладкой. Вернувшись в лабораторию и перепробовав все на вкус, он нашел источник. В 1884 году Фальберг запатентовал сахарин и начал его массовое производство.

4. Кардиостимулятор
В 1956 году Уилсон Грейтбатч занимался разработкой устройства, записывающего удары сердца. Случайно установив в устройство неподходящий резистор, он обнаружил, что оно производит электрические импульсы. Так родилась идея электрической стимуляции сердца. В мае 1958 года первый кардиостимулятор был имплантирован собаке.

ЛСД
Первоначально диэтиламид лизергиновой кислоты планировали использовать в фармакологии (вряд ли кто-то теперь помнит, как именно). В ноябре 1943 года Альберт Хоффман обнаружил странные ощущения во время работы с химикатом. Он описал их так: «Я наблюдал очень яркий свет, потоки фантастических изображений нереальной красоты, сопровождавшиеся интенсивным калейдоскопичным набором цветов». Так Альберт Хоффман сделал миру сомнительный подарок.

6. Пенициллин
Надолго оставив колонию бактерий стафилококка в чашке Петри, Александр Флеминг заметил, что образовавшаяся плесень препятствует росту некоторых бактерий. Химически плесень была разновидностью грибка Penicillium notatum. Так в 40-х годах прошлого века был открыт пенициллин — первый в мире антибиотик.

7. Виагра
Компания Pfizer работала над созданием нового лекарства для лечения сердечных заболеваний. После клинических испытаний выяснилось, что в этом случае новое лекарство вовсе не помогает. Зато есть побочный эффект, которого никто не ожидал. Так появилась виагра.

8. Динамит
Работая с нитроглицерином, который отличался крайней нестабильностью, Альфред Нобель случайно выронил пробирку из рук. Но взрыва не последовало: вылившись, нитроглицерин впитался в древесную стружку, которой был устлан пол лаборатории. Так будущий отец Нобелевской премии понял: нитроглицерин необходимо смешивать с инертным веществом — и получил динамит.

9. Небьющееся стекло
Неаккуратность другого ученого позволила совершить еще одно открытие. Француз Эдуард Бенедиктус уронил на пол пробирку с раствором нитрата целлюлозы. Она разбилась, но не разлетелась на куски. Нитрат целлюлозы стал основой для первых небьющихся стекол, без которых теперь не обходится автомобильная промышленность.

10. Вулканизированная резина
Однажды Чарльз Гудьир вылил азотистую кислоту на каучук, чтобы его обесцветить. Он заметил, что после этого каучук стал гораздо тверже и одновременно пластичнее. Поразмыслив над результатом и усовершенствовав метод, в 1844 году Чарльз Гудьир запатентовал его, назвав в честь Вулкана, древнеримского бога огня.


Посетители, находящиеся в группе Гости, не могут оставлять комментарии к данной публикации.